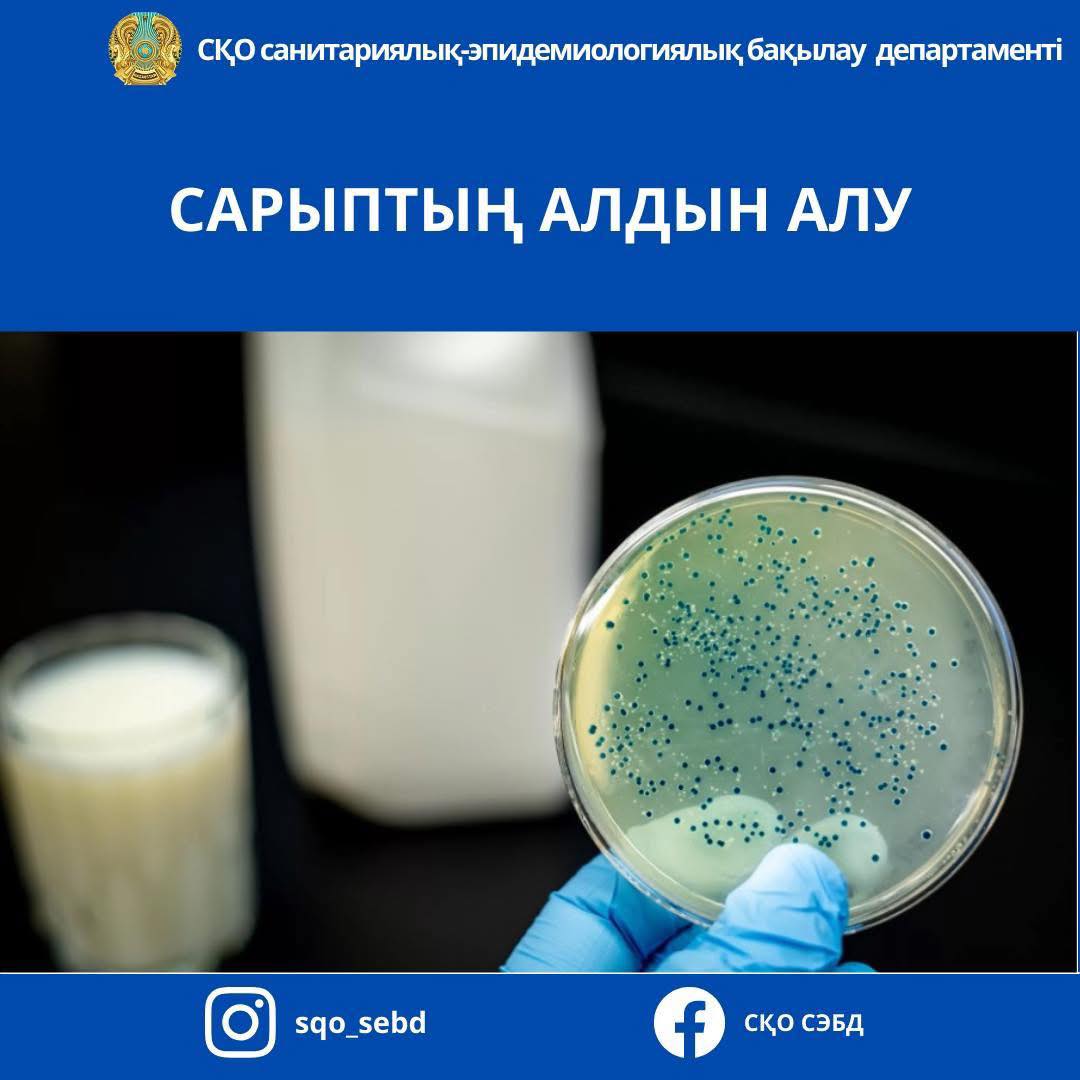
Сарыптың алдын алу

Сарып – адамдар мен жануарлардың жүйке жүйесі мен тірек – қимыл аппаратын зақымдайтын, ұзаққа созылатын жұқпалы ауру.

Сарып ауруының алғашқы белгілері жалпы ауырсыну, дене қызуының 39 - 40°С дейін көтерілуімен басталады. Науқас әлсіздікке, басының, буындарының ауырсынуына шағымданады. Ауру шамамен 3 айға созылады, бірақ 1 – 2 жылға дейін ұзаруы да мүмкін.

Адамға сарып ауруының жұғу жолдары әр түрлі. Инфекция негізінен ауру малды күту немесе сою кезінде жанасу жолы арқылы, сондай-ақ ет, шикі сүт және сүт өнімдерін пайдалану арқылы жұғады. Уақытылы дәрігерге қаралып, емделмеген жағдайда ауру созылмалы түрге өтіп, мүгедектікке және бедеулікке әкелуі мүмкін.

Аурудың негізгі алдын алу шаралары:
- міндетті түрде жылына екі рет малды сарып ауруына тексеріп, ауру анықталған жағдайда 15 күннің ішінде ауру малды жою қажет. Мал ұсталған жерге залалсыздандыру шараларын жүргізу керек, себебі дезинфекциялық препараттар бактерияны түпкілікті жояды;
- ішуге тек қайнатылған сүтті пайдалану керек. Ауру қоздырғышы (бруцелла) 100ºС қайнату температурасында 5 минут ішінде жойылады. Ет, сүт және сүт өнімдерін заңсыз сату орындарынан, белгісіз адамдардан сатып алуға болмайды;
- малға күтім жасау кезінде қарапайым жеке бас гигиенасын сақтау ережелерін сақтау қажет, мал ұстайтын қорада жұмыс жасағаннан кейін қолды міндетті түрде жуу қажет.

Осы күтінімдерді сақтамаған жағдайда адамдар өзінің және жақындарының денсаулығына қатер туғызады.